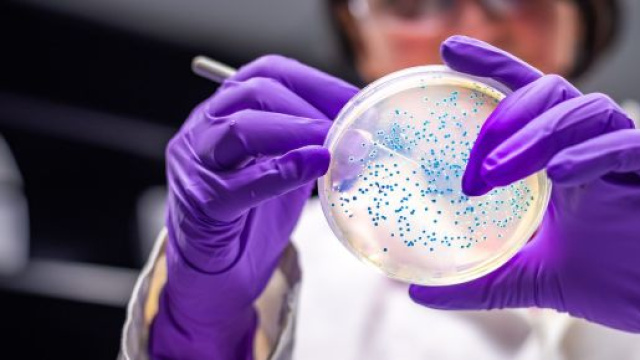
Le ricercatrici italiane che hanno isolato il coronavirus.

Il coronavirus, il virus cinese che si è sviluppato, a partire dallo scorso dicembre, in Cina, ha contaminato più di 4.000 persone e ha provocato ad oggi 363 decessi, di cui uno ad Hong Kong. Il virus risulta essere molto simile alla Sars; quest'ultimo ha provocato 349 morti. I pazienti che, secondo il bollettino del 2 febbraio, sono guariti sembrano però essere più numerosi. Due giorni fa tre ricercatrici italiane della struttura di malattie infettive Spallanzani a Roma, sono riuscite ad isolare il virus. Ora possono iniziare le ricerche della cura e del vaccino in grado di sconfiggere il coronavirus.
In questo modo le tre giovani donne sono riuscite a guadagnarsi la stima da parte della popolazione mondiale. Una delle donne è Francesca Colavita, una 30enne ricercatrice precaria.
Le tre ricercatrici dello Spallanzani
Tre giovani ricercatrici della struttura di malattie infettive Spallanzani di Roma hanno prontamente isolato il virus in una provetta, in seguito alle analisi svolte sui casi dell'Hotel Palatino di via Cavour. Una delle tre donne, la più giovane, è Francesca Colavita, 32enne precaria di Campobasso con un contratto determinato fino al prossimo novembre 2021. La ragazza si è laureata all'università La Sapienza di Roma e lavora da quasi 6 anni nei laboratori dello Spallanzani. La giovane ricercatrice si era impegnata anche durante l'epidemia di Ebola, partendo per la Sierra Leone e per la Liberia.
Francesca era di turno quando è successo l'accaduto e, molto emozionata, ha affermato che è stato più facile del previsto.
Nella squadra era presente anche Maria Rosaria Capobianchi. Quest'ultima è la coordinatrice del team che si è occupato di isolare il coronavirus. Maria Rosaria ha 67 anni ed è originaria di Procida; la donna da 20 anni dirige il reparto di virologia dell'istituto clinico Spallanzani. Maria Rosaria si è laureata in genetica umana e ha concluso gli studi, prendendo una specialistica in virologia. L'altra donna presente era Concetta Castilletti, 56 anni e madre di due figli. Concetta è responsabile del laboratorio di virus emergenti. La donna ha maturato esperienza con virus importanti quali: Sars, H1N1, anche detta influenza suina, Ebola e Zika.
La scoperta nella notte
La scoperta del virus è avvenuta nella notte, quando nel laboratorio di massima sicurezza, si stavano analizzando le cellule del paziente cinese infetto, al momento ricoverato. Il coronavirus, durante l'analisi al microscopio, ha fatto notare che riesce a moltiplicarsi e ad avanzare rapidamente, intaccando le cellule aggredite e alterandone la forma. Il virus odierno, ceppo della famiglia dei coronavirus, sembra essere meno aggressivo di quanto era stato previsto.